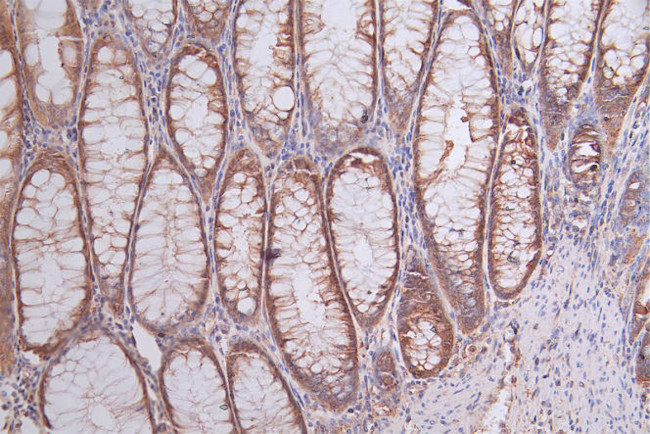
HSP90 beta Antibody in Immunohistochemistry (Paraffin) (IHC (P))

Search
Invitrogen
HSP90 beta Recombinant Rabbit Monoclonal Antibody (7F4)
{{$productOrderCtrl.translations['antibody.pdp.commerceCard.promotion.promotions']}}
{{$productOrderCtrl.translations['antibody.pdp.commerceCard.promotion.viewpromo']}}
{{$productOrderCtrl.translations['antibody.pdp.commerceCard.promotion.promocode']}}: {{promo.promoCode}} {{promo.promoTitle}} {{promo.promoDescription}}. {{$productOrderCtrl.translations['antibody.pdp.commerceCard.promotion.learnmore']}}
图: 1 / 3
HSP90 beta Antibody (MA5-60700) in IHC (P)



Please note: We are reviewing Western blot images included in the antibody testing data in our catalog, including those provided by third parties. Unless expressly labeled or annotated as “raw-unedited”, Western blot images included in the antibody testing data in our catalog may have been edited, optimized or otherwise adjusted for presentation.
产品信息
MA5-60700
种属反应
宿主/亚型
Expression System
分类
类型
克隆号
抗原
偶联物
形式
浓度
规格
纯化类型
保存液
内含物
保存条件
运输条件
RRID
靶标信息
Heat shock proteins (HSP) are expressed in response to various biological stresses, including heat. HSP90 is a 90 kDa protein that is induced under stress conditions, but is also one of the most abundant cellular proteins found under non-stress conditions. HSP90 proteins are highly conserved molecular chaperones that have key roles in signal transduction, protein folding, protein degradation, and morphologic evolution. HSP90 proteins normally associate with other cochaperones and play important roles in folding newly synthesized proteins or stabilizing and refolding denatured proteins after stress. HSP90 has been found to be associated with a number of other intracellular proteins, including steroid receptors, actin, tubulin, aryl hydrocarbon (Ah) receptor, and some kinases.
仅用于科研。不用于诊断过程。未经明确授权不得转售。
篇参考文献 (0)
生物信息学
蛋白别名: Heat shock 84 kDa; Heat shock protein; Heat shock protein family C member 3; Heat shock protein HSP 90-beta; HSP; HSP 84; HSP 90; RP1-302G2.1
基因别名: HSP90AB1; HSP90B; HSPC2; HSPC3; HSPCB
Entrez Gene ID: (Human) 3326